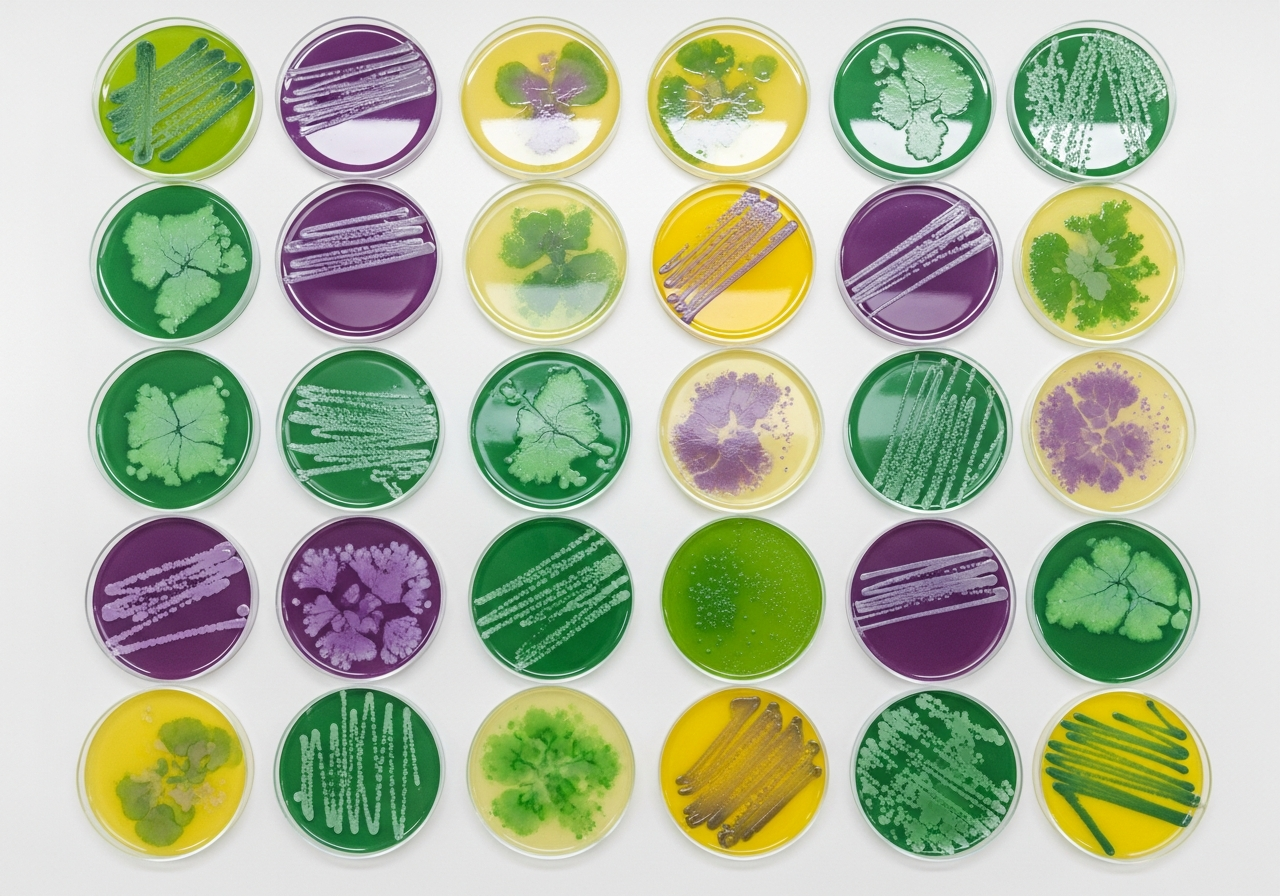
Sustainable Biotech: Green Solutions for a Changing World

Insights & Research
Stay updated with the latest advancements in biotechnology, research insights, and industry best practices from our team of experts.

Modern Laboratory Techniques: Advancing Scientific Research
Explore how modern laboratory techniques are transforming the landscape of scientific research and opening new possibilities for discoveries.

The Future of Customized Research in Biotechnology
Learn how advances in data analytics are enabling tailored research approaches that consider individual project requirements.
Sustainable Biotech: Green Solutions for a Changing World
Discover how biotechnology is contributing to environmental sustainability through biofuels, biodegradable materials, and more.

Best Practices for Laboratory Equipment Maintenance
A comprehensive guide to maintaining your laboratory equipment for optimal performance and longevity.

Building the Next Generation of Biotech Scientists
How educational programs and mentorship initiatives are shaping the future of biotechnology research talent.

Collaborative Research: Breaking Down Institutional Barriers
Insights on how cross-institutional collaboration is supporting scientific discovery and innovation.